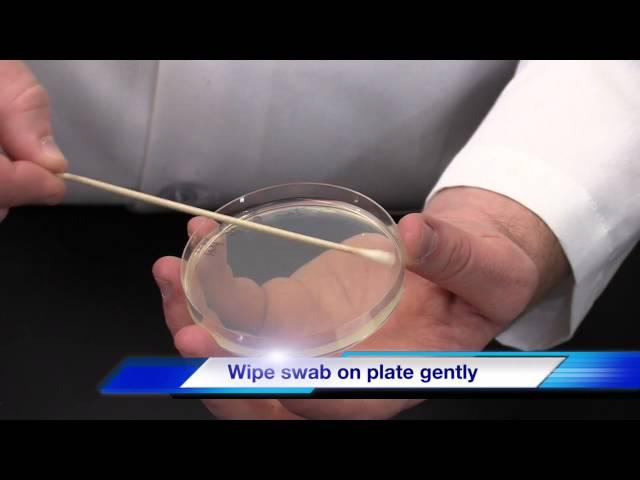

Комментарии:
Kirby Bauer Disk Diffusion Method
Flipped Lab Videos
MBO ft. CeeJayBand$ - Pop Out (Exclusive Music Video) || Dir. IceyyFilms
Thizzler On The Roof
سریعترین و بهترین راه برای رسیدن به اهداف (از منظرقوانین جذب و ذهن)
سید سعید تقوی زاده | موفقیّت
Renaming your files with presets - Kyno tutorial
Lesspain Software
Рекламный анимационный ролик. Шаблон рекламного анимационного ролика.
Заказать рекламный ролик
#happynewyear #happynewyear2025 #numerologytarotreading #tarot #numerology
The Dancing Oracle with Najia

![費玉清 - 一翦梅 Yu-Ching Fei- Yi Jian Mei (xue hua piao piao bei feng xiao xiao)[Official Lyric Video] 費玉清 - 一翦梅 Yu-Ching Fei- Yi Jian Mei (xue hua piao piao bei feng xiao xiao)[Official Lyric Video]](https://ruvideo.cc/img/upload/d2Q3U3ZsZjJxS1Y.jpg)


















